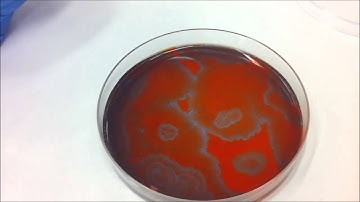
Experimental BELOUSOV-ZHABOTINKSY REACTION-DIFFUSION SYSTEM

⬇ DOWNLOAD NOW
Kalau muncul iklan pop-up, tutup lalu klik tombol kembali
Download lagu Live Stream #39: Q&A and Reaction Diffusion Algorithm secara gratis hanya untuk keperluan promosi. Dukung artis favorit kamu dengan membeli musik original di iTunes atau platform resmi lainnya.
 Coding Challenge #13: Reaction Diffusion Algorithm in p5.js
Coding Challenge #13: Reaction Diffusion Algorithm in p5.js
 2D Reaction Diffusion (F = 0.014, k = 0.039)
2D Reaction Diffusion (F = 0.014, k = 0.039)
 Pattern formation with Reaction-Diffusion Equations. Turing's Morphogenesis.
Pattern formation with Reaction-Diffusion Equations. Turing's Morphogenesis.
 Turing's Reaction-Diffusion System - 2 by Shigeru Kondo
Turing's Reaction-Diffusion System - 2 by Shigeru Kondo
 Reaction Diffusion Algorithm in Processing
Reaction Diffusion Algorithm in Processing
Experimental BELOUSOV-ZHABOTINKSY REACTION-DIFFUSION SYSTEM
Experimental BELOUSOV-ZHABOTINKSY REACTION-DIFFUSION SYSTEM
 Reaction Diffusion Real
Reaction Diffusion Real
 Ginzburg-Landau equation in the form of a reaction-diffusion system
Ginzburg-Landau equation in the form of a reaction-diffusion system